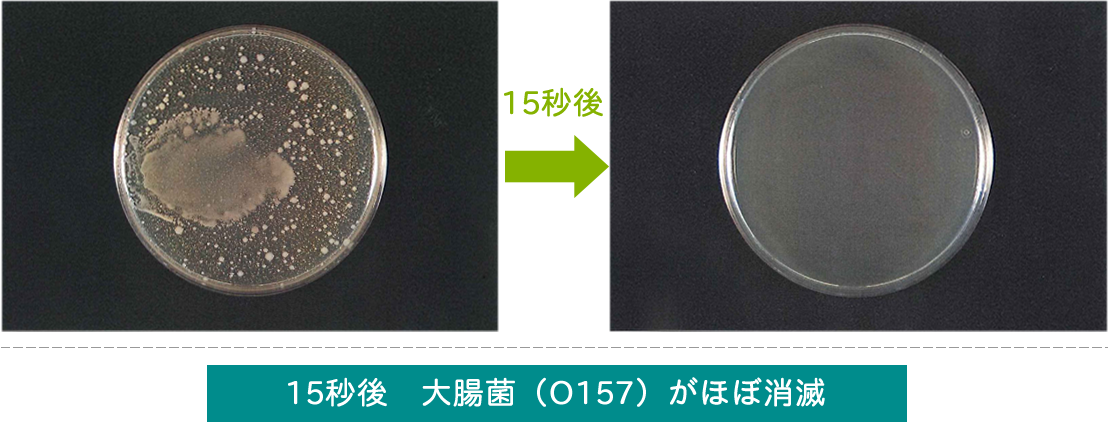

水なのに除菌・消臭ができる、水道水と同じように安心安全な除菌水・消臭水です。
薬品を使用していない安全な水なので、間違ってお口に入れても害はありません。
その為、赤ちゃんやペットのいるご家庭内でも幅広く安心してご利用いただけます。

調理器具や場所の衛生は、細心の注意が必要なところ。
まな板・包丁、箸などの調理用具をはじめ、フキン・食器・排水口・レンジフード,冷蔵庫内など、徹底除菌を。

バスやトイレ周りなど、湿度の高い場所は、カビなどの温床に。
洗濯機の裏側など、手の届かない場所の除菌に活躍します。
また、歯磨き前の歯ブラシ除菌も習慣づけましょう。

いつも清潔にしておきたい食卓テーブル、家族みんながふれるドアノブ、臭いや埃を吸い込むカーテン、細心の注意を払いたい赤ちゃんの玩具、クリーニングがしずらい靴やブーツの内側など、除菌・消臭をしたい場所はいろいろです。
また、水のない場所での手洗い、気になる場所の除菌など、携帯してご活用ください。

人体に害のない水は、もちろんペットにも無害です。
ブラッシングのときなど、全身にこの水を吹きかけてブラッシングをしてあげると、除菌とともにニオイも抑えられます。犬や猫ちゃんも清潔が大好きです!
ペットや家族が一緒に過ごすリビングや快適に過ごしたい寝室などにもご利用ください。

外出時に携帯して、人の出入りが多い公共施設やオフィス、車内・公衆トイレの便座など、気になる所にスプレーすることで、除菌できます。
また、上記の用途以外でも加湿器で使用する事で、タンク内のカビの発生を抑えるなど、生活の様々なシーンの消臭・除菌に活用頂けます。

セット内容
本商品(300mlスプレー付き)2本+
詰替用(300ml)4本 = 合計6本
ご注文はおひとり様1セット限定でお願いいたします
アクアキラがいかに安全で、高い除菌効果が得られるかは、様々な専門機関で科学的に証明されています。